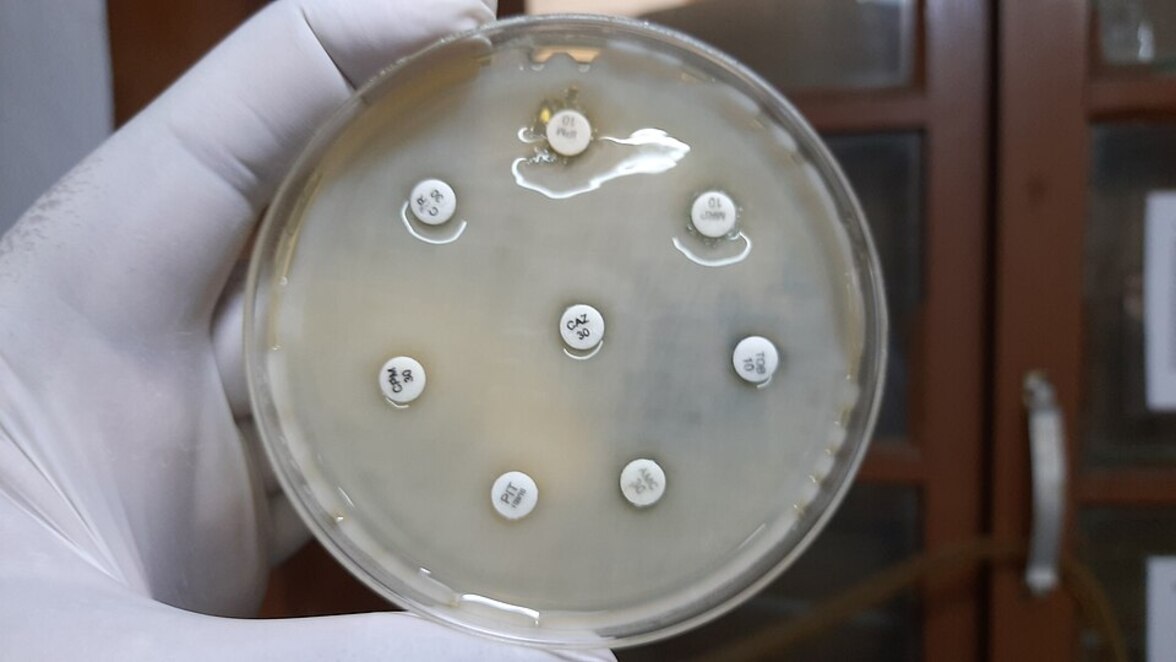
Резистентность, передаваемая плазмидами, способствует глобальному распространению опасных штаммов клебсиеллы

Рост устойчивости к противомикробным препаратам представляет серьезную проблему для здравоохранения во всем мире. Появление устойчивости к карбапенемам вызывает особую обеспокоенность, поскольку эти препараты часто считаются последним средством эффективной терапии инфекций, вызываемых грамотрицательными бактериями с множественной лекарственной устойчивостью.
Из-за отсутствия эффективных методов лечения устойчивые к карбапенемам энтеробактерии (CRE) были классифицированы Всемирной организацией здравоохранения как опасные патогены. Устойчивая к карбапенемам Klebsiella pneumoniae (CRKP) является наиболее часто встречающимся заболеванием легких и вносит значительный вклад в глобальное бремя заюолеваний. Общий уровень смертности, связанный с инфекциями, вызванными CRKP, колеблется от 24,2% до 33%. Только в Европе бета-лактамазы расширенного спектра действия (ESBL) и CRKP являются причиной более 90 000 инфекций и более 7 000 смертей ежегодно. Следовательно, лечение инфекций, вызванных K. pneumoniae, становится все более сложным, а оптимальные терапевтические стратегии остаются неясными. Колистин и тигециклин в настоящее время являются одними из немногих антибиотиков, доступных для лечения тяжелобольных пациентов с инфекциями CRKP. Однако недавнее открытие гена устойчивости к колистину mcr-1, опосредованного плазмидами, представляет серьезную угрозу для клинической эффективности колистина для лечения этих инфекций, в результате чего тигециклин остается одним из немногих вариантов лечения.
Тигециклин, препарат из класса антибиотиков глицилциклинового ряда, классифицируется как критически важный противомикробный препарат и резервный препарат в перечне важных с медицинской точки зрения противомикробных препаратов в классификационном списке ВОЗ AWaRe. Поэтому возникновение резистентности к тигециклину вызывает все большую озабоченность. До 2019 года механизмы резистентности к тигециклину у грамотрицательных бактерий были в основном связаны со сверхэкспрессией хромосомальных эффлюксных систем, мутациями в сайтах связывания рибосом и мутациями tet(A).
Однако недавно были выявлены два новых опосредованных плазмидами механизма резистентности к тигециклину: ферменты, разрушающие тетрациклин (варианты Tet(X)), и эффлюксная система (RND) (TMexCD1-TOprJ1). Эти механизмы были впервые выявлены у бактерий животного происхождения и они представляют значительную угрозу эффективности тигециклина против инфекций, вызываемых K. pneumoniae. В отличие от вариантов Tet(X), которые гидролизуют только тетрациклин и распространены в Escherichia coli и Acinetobacter spp, TMexCD1-TOprJ1 может вызывать устойчивость ко всем тетрациклинам и нескольким другим важным противомикробным препаратам, включая хинолоны, цефалоспорины и аминогликозиды, главным образом у K. pneumoniae. На сегодняшний день идентифицировано шесть кластеров генов, подобных tmexCD-toprJ, переносимых плазмидами, причем tmexCD1-toprJ1 обеспечивает наивысший уровень резистентности к тигециклину, увеличивая минимальные ингибирующие концентрации (МИК) в 16-32 раза. Напротив, другие кластеры увеличили показатели МИК только в 4-8 раз.
Передача генов резистентности к противомикробным препаратам (ARG) происходит через клональные штаммы или мобильные генетические элементы между людьми, животными, продуктами питания и окружающей средой. Как только определенные ARG появляются у животных или человека, они могут распространяться в различных экологических нишах. Учитывая клиническую важность тигециклина и риски для здоровья, связанные с K. pneumoniae, появление K. pneumoniae, продуцирующих TMexCD1-TOprJ1, у животных, употребляемых в пищу, привлекло значительное внимание. Китайские эпидемиологические данные указывают на то, что TMexCD1-TOprJ1 в основном обнаруживается на птицефабриках, но он также был обнаружен в пробах от людей, пищевых продуктах и из окружающей среды. Поэтому понимание механизмов передачи tmexCD1-toprJ1 через экосистемы и эволюционных характеристик переносчиков имеет решающее значение. Однако на сегодняшний день не проводилось крупномасштабных молекулярно-эпидемиологических исследований tmexCD1-toprJ1.
В данном исследовании, опубликованном в журнале Engineering, китайские ученые провели первый общенациональный эпиднадзор за tmexCD1-toprJ1-положительными изолятами из различных экологических ниш, включая сельскохозяйственных животных, окружающую среду, розничную торговлю мясом и людей в Китае. Кроме того, авторы включили для анализа последовательности всего генома tmexCD1-toprJ1-позитивных штаммов из GenBank. Полученные результаты выявили обширную множественную лекарственную резистентность у бактерий, имеющих tmexCD1-toprJ1, с признаками клональной передачи как у людей, так и у кур. Кроме того, ученые наблюдали значительное снижение распространенности tmexCD1-toprJ1 в период с 2018 по 2022 год, что коррелирует с реализацией политики, ограничивающей использование противомикробных препаратов в качестве стимуляторов роста сельскохозяйственных животных в Китае. Это открытие подчеркивает важность политики управления противомикробными препаратами в борьбе с распространением генов устойчивости.
Результаты этого исследования обращают внимание на необходимость постоянного мониторинга tmexCD1-toprJ1 в различных экологических нишах и проведения строгой антимикробной политики в животноводстве.